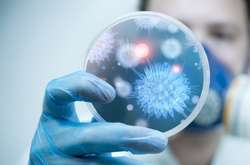
Нове дослідження показало, що інкубаційний період китайського коронавірусу може досягати 24 днів

Трамп передрік кінець епідемії коронавірусу

На думку Трампа, спека вбиває цей тип вірусу та епідемія зійде нанівець у квітні
Президент США Дональд Трамп передрік кінець епідемії нового типу коронавірусу 2019-nCoV.
Про це повідомляє телеканал CNN.
За словами Трампа, епідемія коронавірусу зійде нанівець у квітні.
«Взагалі кажучи, спека вбиває цей тип вірусу. Це було б добре», - сказав Трамп.
Також він зазначив, що Китай «добре справляється» з коронавірусом, незважаючи на поширення хвороби та зростання кількості летальних випадків.
Нагадаємо, раніше посольство України в КНР повідомило, що через розповсюдження вірусу уряд України вирішив евакуювати громадян України з провінції Хубей, у якій запроваджено карантин. Спеціальний чартерний рейс за маршрутом «Київ — Ухань — Київ» був запланований на 11 лютого.
Також нагадаємо, що за прогнозами МОЗ, кількість хворих на коронавірус українців може зрости.
Нагадаємо, сьогодні підтвердилася інформація про другого зараженого українця. Обидва заражених вже покинули корабель і переведені в японську лікарню. Там вони будуть перебувати в ізоляції під відповідним медичним наглядом не менше 14 днів.
9 лютого Міністерство охорони здоров'я України повідомило про перший випадок зараження українця коронавірусом. Чоловік був знятий з лайнера Diamond Princess, який перебуває на карантині біля берегів Японії, та перевезений до японської лікарні столичного регіону. Там він буде перебувати в ізоляції під відповідним медичним спостереженням щонайменше 14 днів.
За останніми даними, число жертв коронавирусу становить 908 осіб. Кількість інфікованих на материковому Китаї зросла 40 тисяч людей. Ще 64 випадки зараження підтверджені в Гонконзі, Макао і на Тайвані; 632 пацієнти виписані з лікарень.
Напередодні ВООЗ відправила в Китай групу експертів через епідемію коронавірусу.
Як відомо, для боротьби із подальшим розповсюдженням спалаху китайського коронавірусу та захисту вразливих держав Всесвітній організації охорони здоров’я потрібно $675 мільйонів.
На думку науковців, пік коронавірусу припаде на другу половину лютого.

Коментарі — 0